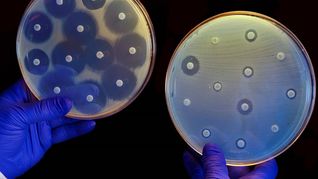
Un modelo de inteligencia artificial permitió diseñar nuevas moléculas contra bacterias resistentes. Un modelo de inteligencia artificial permitió diseñar nuevas moléculas contra bacterias resistentes.

24 de febrero 2011 - 12:15
La manera más loca de cambiar las ruedas del auto
-
Brutal ataque en Misiones: un nene de 7 años fue mordido por siete perros y permanece internado con graves heridas
-
Chau peaje manual en CABA: desde el 1 de mayo sólo se pagara con Telepase

Dejá tu comentario